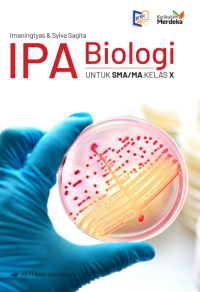
Image of IPA BIOLOGI UNTUK SMA/MA KELAS X KURIKULUM MERDEKA

Text
IPA BIOLOGI UNTUK SMA/MA KELAS X KURIKULUM MERDEKA
Tidak Tersedia Deskripsi
Ketersediaan
| 55288 | My Library | Tersedia | |
| 55289 | My Library | Sedang Dipinjam (Jatuh tempo pada2026-11-25) | |
| 55290 | My Library | Tersedia | |
| 55291 | My Library | Tersedia | |
| 55292 | My Library | Tersedia | |
| 55293 | My Library | Sedang Dipinjam (Jatuh tempo pada2026-11-25) | |
| 55294 | My Library | Tersedia | |
| 55295 | My Library | Sedang Dipinjam (Jatuh tempo pada2026-07-24) | |
| 55296 | My Library | Tersedia | |
| 55297 | My Library | Sedang Dipinjam (Jatuh tempo pada2026-07-24) | |
| 55298 | My Library | Tersedia | |
| 55299 | My Library | Tersedia | |
| 55300 | My Library | Tersedia | |
| 55301 | My Library | Tersedia | |
| 55302 | My Library | Tersedia | |
| 55303 | My Library | Tersedia | |
| 55304 | My Library | Tersedia | |
| 55305 | My Library | Tersedia | |
| 55306 | My Library | Tersedia | |
| 55307 | My Library | Tersedia | |
| 55308 | My Library | Tersedia | |
| 55309 | My Library | Tersedia | |
| 55310 | My Library | Tersedia | |
| 55311 | My Library | Sedang Dipinjam (Jatuh tempo pada2026-07-24) | |
| 55312 | My Library | Sedang Dipinjam (Jatuh tempo pada2026-11-25) | |
| 55313 | My Library | Tersedia | |
| 55314 | My Library | Tersedia | |
| 55315 | My Library | Tersedia | |
| 55316 | My Library | Tersedia | |
| 55317 | My Library | Tersedia | |
| 55318 | My Library | Tersedia | |
| 55319 | My Library | Tersedia | |
| 55320 | My Library | Tersedia | |
| 55321 | My Library | Sedang Dipinjam (Jatuh tempo pada2026-11-25) | |
| 55322 | My Library | Tersedia | |
| 55323 | My Library | Tersedia | |
| 55324 | My Library | Tersedia | |
| 55325 | My Library | Sedang Dipinjam (Jatuh tempo pada2026-11-25) | |
| 55326 | My Library | Tersedia | |
| 55327 | My Library | Tersedia | |
| 55328 | My Library | Tersedia | |
| 55329 | My Library | Tersedia | |
| 55330 | My Library | Tersedia | |
| 55331 | My Library | Sedang Dipinjam (Jatuh tempo pada2026-07-31) | |
| 55332 | My Library | Sedang Dipinjam (Jatuh tempo pada2027-04-20) | |
| 55333 | My Library | Sedang Dipinjam (Jatuh tempo pada2026-11-25) | |
| 55334 | My Library | Sedang Dipinjam (Jatuh tempo pada2026-11-25) | |
| 55335 | My Library | Tersedia | |
| 55336 | My Library | Tersedia | |
| 55337 | My Library | Sedang Dipinjam (Jatuh tempo pada2026-11-25) |
Informasi Detail
- Judul Seri
-
-
- No. Panggil
-
570 IRN I
- Penerbit
- Jakarta : ERLANGGA., 2025
- Deskripsi Fisik
-
-
- Bahasa
-
- ISBN/ISSN
-
9786231807878
- Klasifikasi
-
570
- Tipe Isi
-
-
- Tipe Media
-
-
- Tipe Pembawa
-
-
- Edisi
-
-
- Subjek
- Info Detail Spesifik
-
-
- Pernyataan Tanggungjawab
-
-
Versi lain/terkait
Tidak tersedia versi lain
Lampiran Berkas
Tidak Ada Data
Komentar
Anda harus masuk sebelum memberikan komentar
 Karya Umum
Karya Umum  Filsafat
Filsafat  Agama
Agama  Ilmu-ilmu Sosial
Ilmu-ilmu Sosial  Bahasa
Bahasa  Ilmu-ilmu Murni
Ilmu-ilmu Murni  Ilmu-ilmu Terapan
Ilmu-ilmu Terapan  Kesenian, Hiburan, dan Olahraga
Kesenian, Hiburan, dan Olahraga  Kesusastraan
Kesusastraan  Geografi dan Sejarah
Geografi dan Sejarah